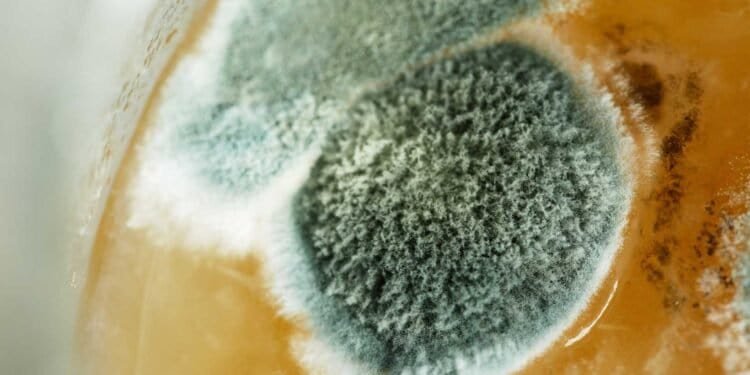
DIY Kits vs. Professional Analysis: Decoding Mold Test Results Explained

Mold is a common problem in many households, and it can lead to serious health issues if left untreated. It is essential to identify the presence of mold in your home and take necessary steps to get rid of it. One way to do this is by using mold testing kits, which are available in the market for DIY testing. However, the accuracy of these kits is often questioned, and many homeowners prefer professional mold inspection and testing.

Understanding the different types of mold tests and analyzing the results can be a daunting task. DIY mold testing kits are relatively inexpensive and convenient, making them an attractive option for many homeowners. However, professional mold inspection and testing provide more accurate results and are recommended for severe mold problems. In this article, we will explore the pros and cons of DIY mold testing kits versus professional mold analysis and help you decode mold test results to make an informed decision.
Key Takeaways
- Professional mold inspection and testing provide more accurate results than DIY mold testing kits.
- Understanding the different types of mold tests and analyzing the results can be a daunting task.
- Prevention and remediation strategies are essential for addressing mold problems in the household.
Understanding Mold and Its Implications

Mold is a type of fungus that grows in warm, damp, and humid conditions. It reproduces by releasing tiny spores into the air, which can easily spread and settle on surfaces. Mold spores are present everywhere, but they only grow into mold colonies when they find the right conditions.
Types of Mold
There are many types of mold, but some of the most common ones found in homes include Stachybotrys, Aspergillus, and Cladosporium. Stachybotrys, also known as black mold, is a toxic mold that can cause serious health problems. Aspergillus can cause allergies and respiratory problems, while Cladosporium is a common outdoor mold that can trigger allergies.
Health Risks Associated with Mold
Exposure to mold can cause a variety of health problems, especially for people with allergies or weakened immune systems. Some of the health risks associated with mold include respiratory problems, allergic reactions, and skin irritation. In addition, some types of mold produce mycotoxins, which can cause serious health problems if ingested or inhaled.
It is important to note that not all mold is dangerous, and not all people are affected by mold in the same way. However, if you suspect that you have mold in your home, it is important to take action to prevent further growth and protect your health.
DIY Mold Testing Kits
If you suspect the presence of mold in your home or office, DIY mold testing kits are a cost-effective and convenient option to consider. These kits come with all the necessary components to collect samples and test them for the presence of mold.
Components and Usage
DIY mold testing kits typically include swabs, tape strips, or settling plates, along with detailed instructions on how to collect and submit samples. The process typically involves taking a sample from a suspected mold-infested area, such as a wall, ceiling, or air conditioning system, and sending it to a lab for analysis.
Pros and Cons of DIY Testing
One of the main advantages of DIY mold testing is cost-effectiveness. These kits are generally more affordable than professional mold testing services. Additionally, they are user-friendly and do not require any specialized training or equipment.
However, there are some downsides to consider as well. DIY mold testing kits may not be as accurate as professional testing services. They may also miss certain types of mold or fail to detect mold in areas with visible growth. Furthermore, the results may be difficult to interpret without the help of a trained professional.
Interpreting DIY Test Results
Interpreting DIY mold test results can be challenging, especially for those without a background in mold analysis. The results may be presented in a format that is difficult to understand, and it may be unclear what steps to take next.
If you do choose to use a DIY mold testing kit, it is important to carefully follow the instructions and submit the samples to a reputable lab for analysis. Once you receive the results, it may be helpful to consult with a professional mold inspector to help you interpret the results and determine the best course of action.
In summary, DIY mold testing kits are a convenient and cost-effective option for those who suspect the presence of mold in their homes or offices. However, it is important to consider the pros and cons before choosing this option, and to carefully follow the instructions and submit the samples to a reputable lab for analysis.
Professional Mold Inspection and Testing
When to Call a Professional
If you suspect that you have a mold problem in your home, it is essential to call a professional inspector for a thorough assessment. Professional mold inspectors are certified and have specialized training to identify, assess, and test mold growth in your home.
While DIY kits can provide a quick and inexpensive way to test for mold, they do not provide the same level of accuracy and reliability as a professional assessment. Professional inspectors have the experience and specialized equipment necessary to identify the type of mold and the extent of the contamination accurately.
The Inspection Process
During a professional mold inspection, the inspector will conduct a visual inspection of your home and collect samples for lab testing. The inspector will also use specialized equipment to detect moisture and identify areas of potential mold growth.
The inspection process typically takes several hours, depending on the size of your home and the extent of the mold contamination. After the inspection, the inspector will provide you with a detailed report outlining their findings and recommendations for remediation.
Understanding Lab Results
Professional mold testing is conducted in an accredited laboratory, ensuring precision and accuracy in the results. The lab analysis will identify the type of mold present and the extent of the contamination, allowing for effective remediation.
The lab results will also provide recommendations for mold remediation and prevention, providing peace of mind knowing that your home is free from mold contamination.
In summary, while DIY mold kits can be a quick and inexpensive way to test for mold, they do not provide the same level of accuracy and reliability as a professional assessment. Professional mold inspectors have the experience, specialized equipment, and training necessary to accurately identify and assess mold growth in your home, providing peace of mind knowing that your home is free from mold contamination.
Types of Mold Tests
When it comes to testing for mold, there are three main types of tests: air sampling, surface sampling, and bulk sampling. Each type of test has its own advantages and disadvantages, and it’s important to understand the differences so you can choose the right test for your needs.
Air Sampling
Air sampling is one of the most common types of mold tests. This test involves collecting airborne mold spores and analyzing them to determine the type and concentration of mold present in the air. Air sampling can be done in a number of ways, including using a spore trap, a cassette sampler, or a bioaerosol sampler.
One advantage of air sampling is that it can detect mold that is not visible to the naked eye. However, it’s important to note that air sampling only provides a snapshot of the mold present in the air at the time of the test. It does not provide information about mold that may be growing on surfaces or hidden behind walls.
Surface Sampling
Surface sampling involves collecting mold samples from surfaces in your home, such as walls, floors, and ceilings. This type of test can be done using a swab, tape lift, or bulk sample.
One advantage of surface sampling is that it can detect mold that is growing on surfaces in your home. However, it’s important to note that surface sampling only provides information about the mold present on the surface that was tested. It does not provide information about mold that may be present in the air.
Bulk Sampling
Bulk sampling involves collecting a piece of material that may contain mold, such as a piece of drywall or insulation. This type of test can provide information about the concentration of mold present in a particular area.
One advantage of bulk sampling is that it can provide information about the concentration of mold present in a particular area. However, it’s important to note that bulk sampling does not provide information about the types of mold present in the area. It may also be more difficult to interpret the results of a bulk sample compared to other types of tests.
Overall, each type of mold test has its own advantages and disadvantages, and it’s important to choose the right test for your needs. It’s also important to work with a reputable company that can provide accurate and reliable results.
Analyzing Mold Test Results

After conducting mold tests, it’s essential to analyze the results accurately to determine the extent of the mold problem and the appropriate remediation measures. The following subsections detail how to read and interpret mold test results.
Reading the Numbers
Mold test reports often provide numerical data that indicates the concentration of mold spores in the air. The Environmental Protection Agency (EPA) has not established a specific threshold for mold concentration levels, but a high mold concentration level indicates a severe mold problem that requires immediate remediation. On the other hand, low mold concentration levels are typical and do not pose a significant threat to human health.
Identifying Mold Species
The mold species identified in the test results is an essential factor in determining the appropriate remediation measures. Some mold species, such as Penicillium and Cladosporium, are relatively harmless and do not require immediate remediation. However, other mold species, such as Stachybotrys, are dangerous and require immediate remediation.
It’s essential to note that mold test results should be analyzed by a qualified professional to ensure accurate identification of mold species and concentration levels. DIY mold test kits may not provide accurate results, as they do not account for dead spores or provide an overall understanding of mold contamination. Professional analysis is recommended for accurate results and appropriate remediation measures.
Factors Affecting Mold Test Accuracy

Mold testing is a crucial step in identifying and addressing mold growth in homes and buildings. However, the accuracy of mold test results can vary depending on several factors.
Limitations of DIY Kits
DIY mold test kits are readily available and affordable, making them a popular choice for homeowners. However, these kits have limitations that can affect their accuracy. For instance, DIY kits can only detect mold that is visible or present on surfaces. They cannot detect mold growth in hidden areas such as inside walls, ceilings, or floors. As a result, DIY kits may provide false-negative results, giving homeowners a false sense of security.
Moreover, DIY kits are often not as accurate as professional equipment. These kits may produce false positives due to the presence of other substances that resemble mold, such as dust or dirt. Additionally, DIY kits may not account for dead spores, which can also impact health and are not always visible to the naked eye.
Advantages of Professional Equipment
Professional mold testing equipment, on the other hand, offers several advantages that can improve the accuracy of mold test results. Professional equipment can detect mold growth in hidden areas, such as inside walls or under flooring, that DIY kits cannot detect. This equipment can also identify the specific type of mold present, which can help determine the potential health risks associated with the mold.
Professional mold testing equipment is also calibrated and maintained regularly, ensuring accurate results. Professional mold inspectors are trained to interpret the results accurately and can provide homeowners with a comprehensive report detailing the extent of mold growth and recommended remediation steps.
In conclusion, while DIY mold test kits are a convenient and affordable option, they have limitations that can affect their accuracy. Professional mold testing equipment offers several advantages that can improve the accuracy of mold test results and provide homeowners with a more comprehensive understanding of the mold growth in their homes or buildings.
Prevention and Remediation Strategies

Preventing Mold Growth
Preventing mold growth is the best way to avoid costly repairs and remediation. Here are some tips to prevent mold growth:
- Control humidity levels: Keep indoor humidity levels between 30-60%.
- Ventilation: Ensure proper ventilation in areas like the bathroom, kitchen, and laundry room to reduce moisture levels.
- Fix Water Damage: Repair any leaks or water damage immediately to prevent mold growth.
- Regular Cleaning: Regularly clean and inspect areas prone to moisture like the bathroom, kitchen, and basement.
Remediation and Repair
If mold growth is detected, it is important to address the issue immediately to prevent further damage. Here are some tips for mold remediation and repair:
- Safety First: Wear protective gear like gloves, goggles, and a mask to prevent exposure to mold spores.
- Identify the Source: Identify and fix the source of the mold problem to prevent future growth.
- Professional Remediation: For extensive mold growth, it is recommended to hire a professional remediation company to ensure safe and effective removal.
- DIY Remediation: For small areas of mold growth, DIY remediation may be possible using bleach or other cleaning solutions. However, it is important to follow proper safety measures and ensure thorough cleaning to prevent further growth.
In conclusion, preventing mold growth and addressing mold problems immediately is the best way to avoid costly repairs and remediation. Regular cleaning, controlling humidity levels, proper ventilation, and fixing water damage are all important steps in preventing mold growth. When remediation is necessary, it is important to prioritize safety and either hire a professional remediation company or follow proper DIY remediation techniques.
Practical Considerations for Homeowners
Cost-Benefit Analysis
When it comes to mold testing, homeowners must weigh the costs and benefits of DIY kits versus professional analysis. DIY kits are relatively inexpensive, costing anywhere from $10 to $100, and can provide immediate results. On the other hand, professional mold testing can cost upwards of $300 and may take several days to receive results.
While DIY kits may seem like a more cost-effective option, they may not provide accurate results. Homeowners must also consider the potential health risks associated with mold exposure and the impact on their indoor environment.
Making Informed Decisions
Homeowners should consider several factors when deciding whether to use a DIY mold test kit or hire a professional. If the homeowner suspects mold growth in their living space, they should first investigate the source of the problem, such as water damage or humidity issues.
If the homeowner is experiencing musty odors or skin irritation, it may be a sign of a mold problem. In this case, a professional mold inspection may be necessary to identify the type of fungus present and determine the extent of the contamination.
Budget constraints may also play a role in the decision-making process. While DIY kits may seem like a more cost-effective option, they may not provide accurate results and could end up costing more in the long run if the mold problem is not properly addressed.
In conclusion, homeowners must carefully consider their options when it comes to mold testing. While DIY kits may provide immediate results and seem like a more cost-effective option, they may not provide accurate results and could potentially pose a health risk. Professional mold testing may be necessary to properly identify the type of fungus present and determine the extent of the contamination.
Frequently Asked Questions
How can I interpret the results from a home mold test kit?
Interpreting the results of a home mold test kit can be challenging, especially if you are not familiar with the different types of mold. Most DIY mold kits will come with instructions that will help you interpret the results. Typically, the results will show whether mold is present or not, and if it is, the type of mold present.
What are the indicators of a positive mold test result?
A positive mold test result indicates that mold is present in the tested area. The indicators of a positive mold test result include visible mold growth, a musty odor, and respiratory symptoms such as coughing, sneezing, and wheezing.
How do professional mold analysis results differ from DIY mold kit results?
Professional mold analysis results are typically more accurate and reliable than DIY mold kit results. Professional mold testing involves taking air and surface samples, which are then analyzed in a laboratory. The laboratory analysis will identify the type of mold present and the concentration of mold spores in the air or on surfaces. DIY mold kits, on the other hand, are not as accurate and reliable as professional mold testing.
What steps should be taken after a mold test kit shows positive?
If a mold test kit shows positive, it is important to take immediate action to prevent further mold growth and exposure. The first step is to identify the source of the mold and address the underlying cause. This may involve fixing leaks, increasing ventilation, or reducing humidity levels. Once the source of the mold has been addressed, the affected area should be cleaned and disinfected.
How reliable are Mold Armor test kits compared to professional assessments?
Mold Armor test kits are not as reliable as professional assessments. While they can provide an indication of whether mold is present, they are not as accurate or reliable as professional assessments. Mold Armor test kits may yield false negatives or positives, leading to unreliable results.
What are the common signs to look for in a mold test report?
A mold test report will typically include the type of mold present, the concentration of mold spores in the air or on surfaces, and any recommendations for remediation. Common signs to look for in a mold test report include high levels of mold spores, the presence of toxic mold, and recommendations for professional mold remediation.